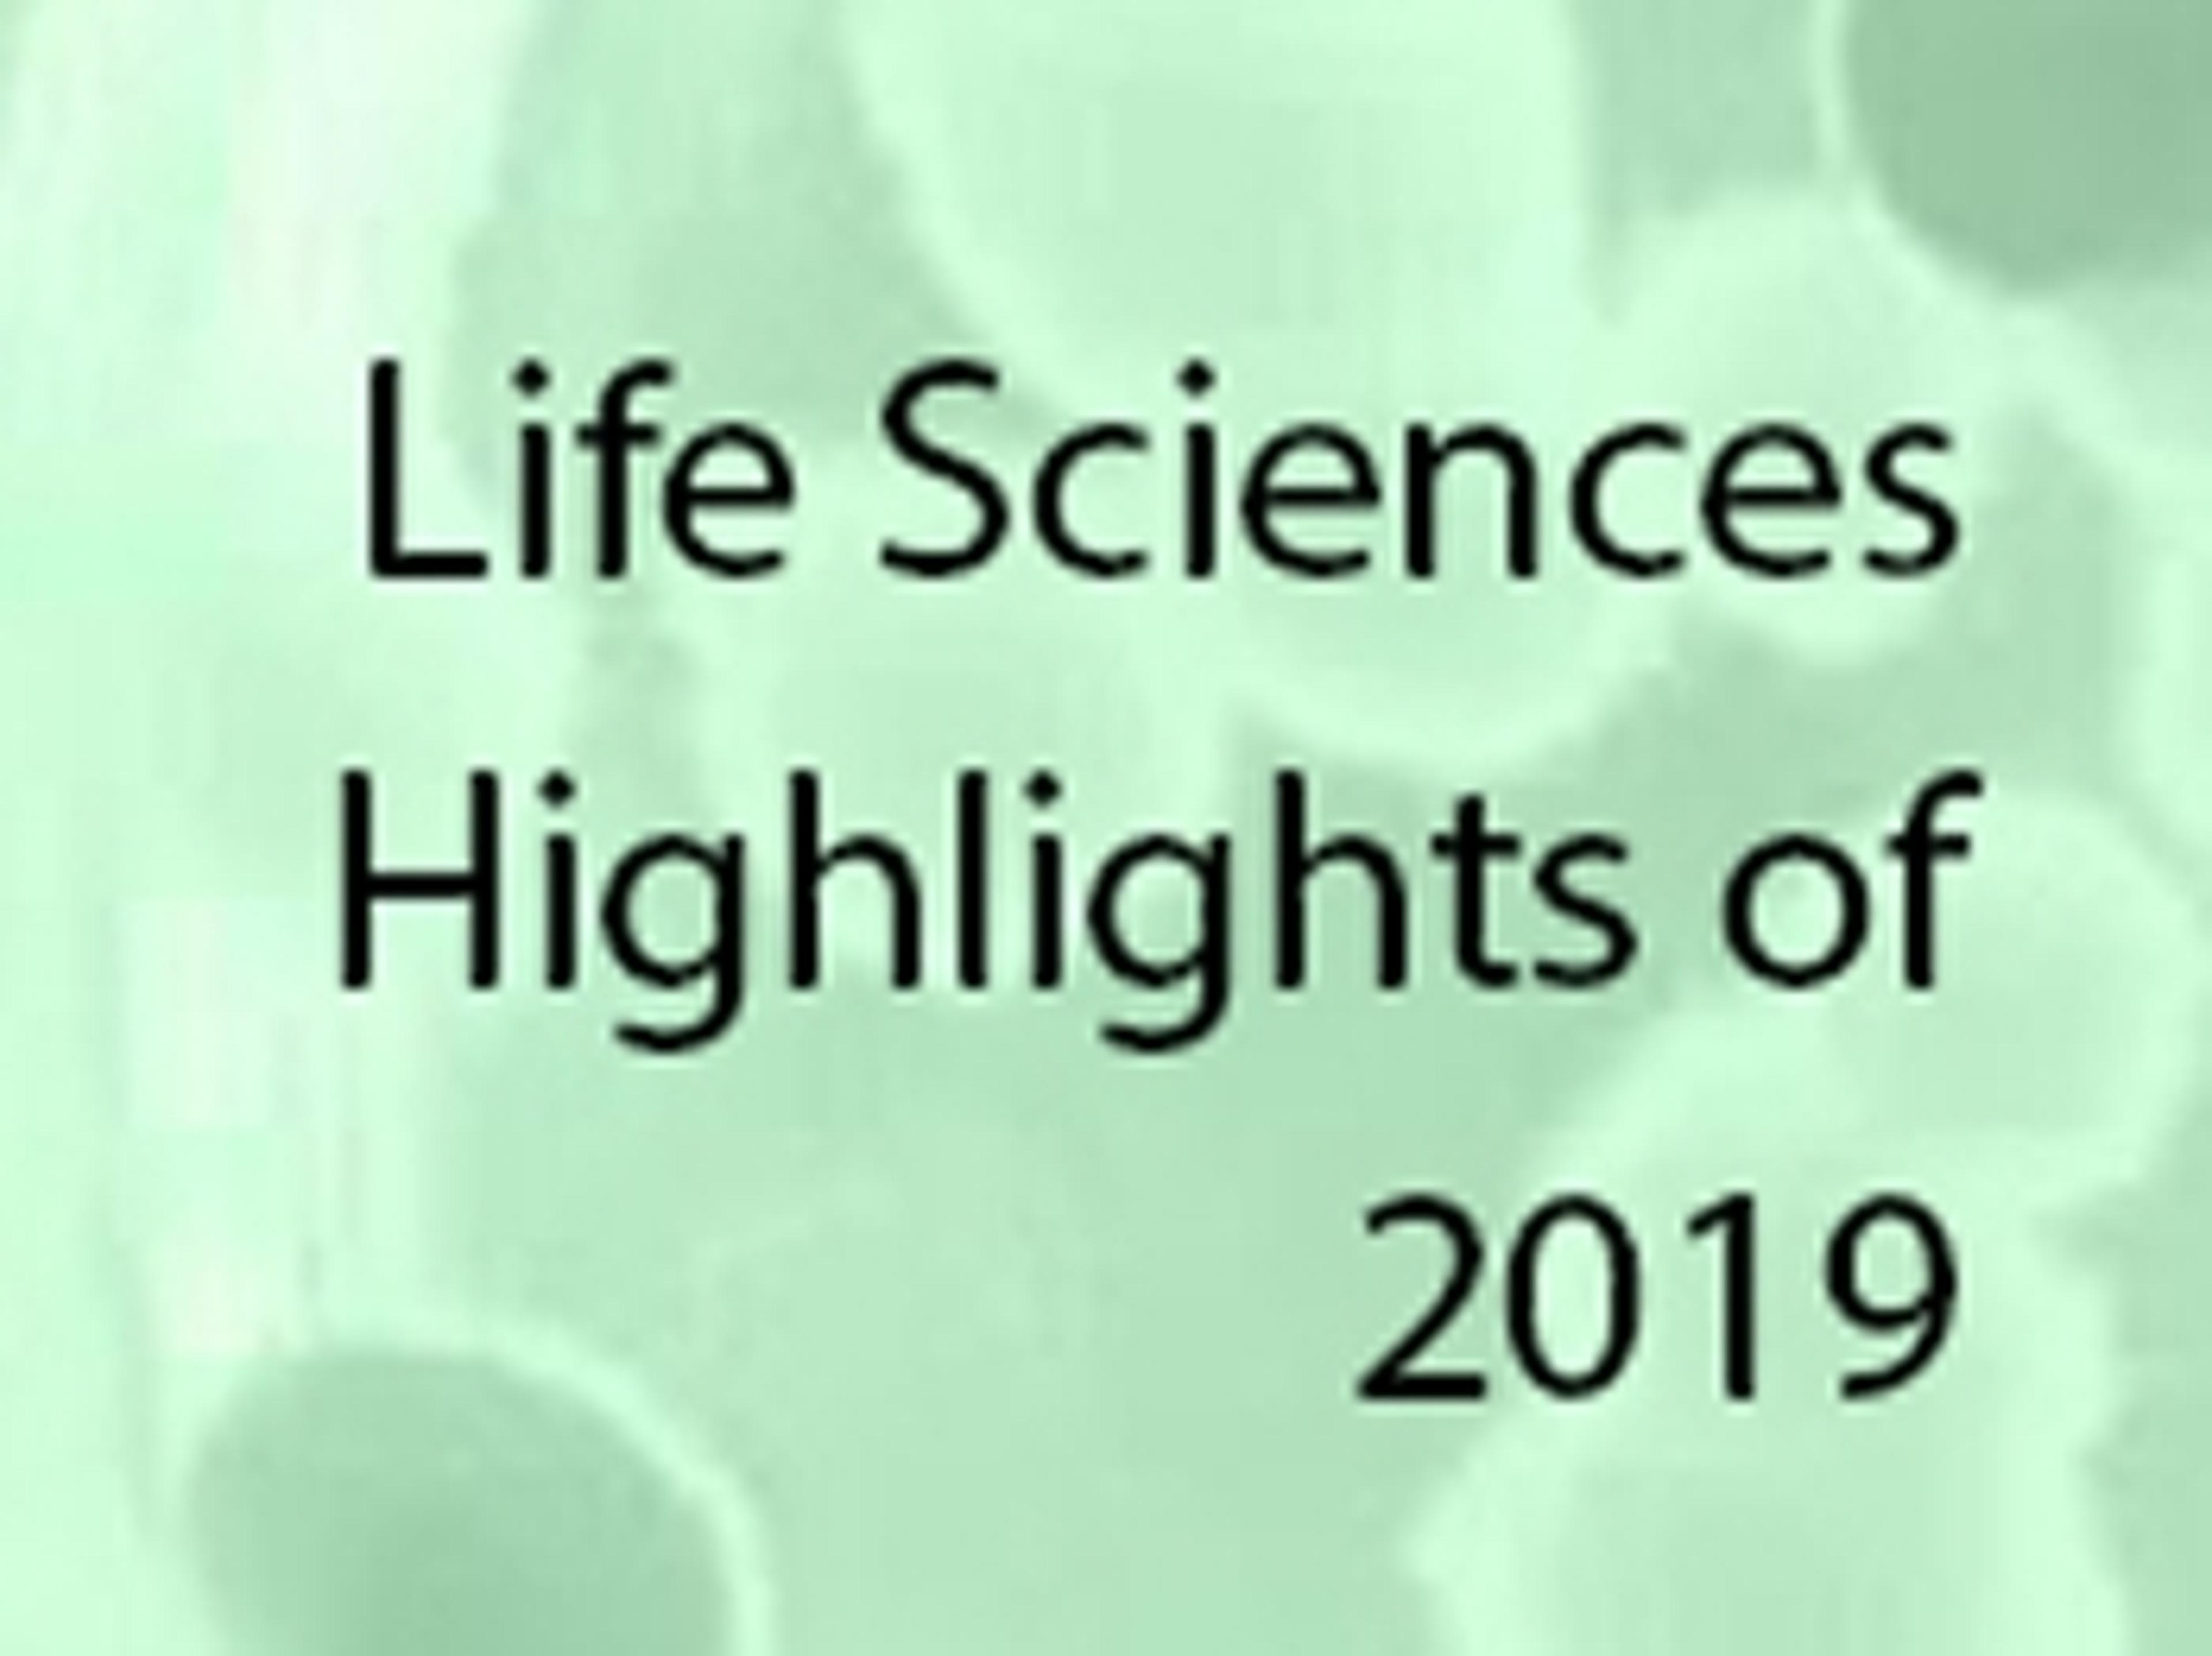

LUNA-FL™ Dual Fluorescence Cell Counter
Accurate cell counts in as little as 7 seconds: Fast, accurate, and affordable automated cell counters from Logos Biosystems.
Reliable and user-friendly
Cell Counting
The Luna-FL is a fantastic product that truly delivers on its promises. Its sleek design and intuitive functionality make it incredibly user-friendly, even for beginners. The performance is consistent and reliable, with a noticeable focus on quality and durability. Whether you're using it for everyday tasks or more advanced applications, it exceeds expectations. Highly recommended for anyone looking for a dependable and efficient solution.
Review Date: 13 Mar 2025 | Logos Biosystems
Excellent product
Nuclei counting for single-cell analysis
I'm using LUNA-FL to count AO/PI stained nuclei for snRNA-seq or scATAC-seq. Very precise and reproducible results, even when using organoid samples (dissociated to single cells). Excellent product.
Review Date: 3 Mar 2025 | Logos Biosystems
Easy to use product
Cell culture and cell counting
Good product. Very easy to use. Requires minimal space.
Review Date: 11 Feb 2025 | Logos Biosystems
Great results and has highly reproducible results!
Blood samples, PMN and PBMC counts.
Great results when you have to analyze several samples. I use it for the extraction of PBMCs an PMNs of complete blood. The equipment is very easy to use and has highly reproducible results.
Review Date: 27 May 2024 | Logos Biosystems
Great counter for cell and nuclei counting
Single nucleus RNA sequencing
Well suited counter for counting single nuclei suspensions from tissue samples. The AO/PI dye stain is great for accurately counting nuclei from samples with high amount of debris. Very easy to use and quick!
Review Date: 15 May 2024 | Logos Biosystems
It's great!
Regular cell counting
This cell counter is useful and has high quality. All the results are producible and consistent.
Review Date: 26 Apr 2024 | Logos Biosystems
Great results, easy to use, reliable
General and Fluorescent Cell Counting
This cell counter is an essential cell culture room piece of equipment. In my experience it is very easy to use. You are able to create different protocols for various fluorophores, trypan blue or no trypan blue, and so on. The interface is also user friendly. I recommend this product for your cell counting needs
Review Date: 12 Mar 2024 | Logos Biosystems
Love it!
Cell counting
Very user friendly and accurate. It saves a lot of time because it's quick, and it's compact so it saves bench space too :)
Review Date: 5 Mar 2024 | Logos Biosystems
It is worth your money, life saver
Cell counting
For cell counting it's very easy to use! I like it! Great product
Review Date: 28 Feb 2024 | Logos Biosystems
Must have
Cell counting
It's really easy to use for cell counting! Great product!
Review Date: 28 Feb 2024 | Logos Biosystems
With four counting modes, the LUNA-FL™ is a powerhouse. Equipped with brightfield and dual fluorescence optics that allows the sensitive detection of most cell types excluding bacteria. The LUNA-FL™ can distinguish primary cells such as PBMCs, splenocytes, neutrophils, and stem cells from undesirable debris for accurate cell count and viability results. Brightfield cell counting, fluorescence cell counting, yeast cell counting, and GFP transfection assays are all in the LUNA-FL™ wheelhouse. This versatile little counter sits comfortably in a cell culture hood or on your benchtop to fit seamlessly into your workflow.
- TWO COUNTERS IN ONE
- The LUNA-FL™ can count in both brightfield and fluorescence mode, making it our most versatile counter to date.
- THE LOWEST COST PER COUNT, THE GREATEST CONVENIENCE
- Whether you use our disposable precision slides for increased convenience or our budget-friendly LUNA reusable slide, our cell counters deliver accurate and reliable counts every. single. time.
- COMPATIBLE WITH MOST CELLS
- Advanced imaging software and GFP and RFP fluorescence optics sensitively detect fluorescence stained cells.
- GFP TRANSFECTION ANALYSIS
- High resolution images are captured and analyzed to detect GFP-positive and -negative cells.
- MAXIMUM 30 SECONDS
- Fluorescence: 30 s = 3 images captured & analyzedBrightfield: 10 s = 1 image captured & analyzed
- Fluorescence: 30 s = 3 images captured & analyzedBrightfield: 10 s = 1 image captured & analyzed
Brochures
LUNA-FL™ automated cell counter
Discover the LUNA-FL™ automated cell counter, a stand-alone compact instrument with combined fluorescence microscopy and image analysis software.
Using the LUNA™ Reusable Slide for accurate cell counting with automated cell counters
In this application note, Logos Biosystems compares the cell counting results of the LUNA™ Reusable Slide, a hemocytometer, and disposable slides.
Automated Fluorescence Cell Counting
This white paper addresses areas of florescence cell counting including fluorescence dyes, applications and a comparison of technologies. The LUNA-FL™ fluorescence cell counter is presented as a solution to overcome limitations associated with cell types.
Fast Cell Counting and Viability Measurement of Yeast Cells with the LUNA-FL™ Fluorescence Cell Counter
This application note analyses the viability of Saccharomyces Cerevisiae stained with Fluorescein diacetate (FDA), a fluorogenic cell viability probe, using the LUNA-FL™, fluorescence cell counter.
GFP Expression Analysis Using the Luna-FL™ Fluorescence Cell Counter
An easy and popular method to measure the transfection efficiency is to use a GFP gene. For example, by making a fusion protein between GFP and the protein of interest, the expression of the protein of interest can be measured by the presence of GFP protein. This application note demonstrates that the Luna-FL™, is suitable for the measurement of GFP transfection efficiency.
Real-world approaches to sample QC in single-cell and nucleus prep
June 12, 2025 – 15:00 BST / 16:00 CEST / 10:00 EDT / 07:00 PDT
As single-cell and multiomics technologies continue to reshape our understanding of complex biology, the importance of high-quality sample preparation has never been greater. Reliable quality control (QC) is essential to ensure that valuable samples - often limited and difficult to obtain - yield meaningful, reproducible data. However, researchers working with diverse sample types, such as frozen or FFPE tissue, often face significant QC challenges.
In this webinar, experts from both academia and industry share real-world approaches to QC in single-cell and nucleus workflows, a critical step for ensuring the success of downstream applications such as single-cell RNA sequencing (RNA-seq) and multiomics analysis.
The expert speakers will show how the LUNA-FX7™ automated cell counter enables accurate and reproducible QC, even in challenging samples with high debris levels or low yield. Through advanced imaging and algorithm-based classification, you will see how the FX7 supports reliable assessment of nuclei and cell concentration and viability – with data from a range of sample types including fresh, frozen, fixed, and FFPE preparations.
Key learning objectives:
- Explore real-world applications for improving sample quality in single-cell and nuclei workflows.
- Gain insights into accurate assessment of sample concentration and viability using the LUNA-FX7™ automated cell counter.
- Learn practical approaches for handling challenging samples such as fixed and FFPE preparations.
Who should attend?
From students and professors to lab technicians, managers, and chief scientific officers, covering academia, government, and private sector businesses and industries.
Certificate of attendance
All webinar participants can request a certificate of attendance, including a learning outcomes summary, for continuing education purposes. If you view the on-demand webinar, you can request a certificate of attendance by emailing editor@selectscience.net.
Automated Nuclei QC Enhances Single Cell Sequencing
To achieve desired and reliable outcomes in single cell sequencing, the accurate evaluation of nuclei quality is critical. Choosing the most effective method and choosing the right combination of dyes is not easy.
In this webinar, you will learn how to streamline nuclei assessments and choose optimal fluorescent dyes combinations. In addition, you will discover how to integrate the different dyes and optimize advanced automated cell counters to ensure the reliability of results.
Key learning objectives
- Learn how to streamline nuclei quality assessments for downstream applications such as single cell genomics research
- Find out the optimal fluorescent dye combinations for ensuring the quality and reliability of nuclei assessments
- Understand the capabilities of automated cell counters (like that of the LUNA-FX7™ and LUNA-FL™) as powerful tools for precise nuclei assessments
Who should attend?
Students, graduate students, doctoral students, post doc researchers, assistant/associate professors, professors, lab technicians, lab specialists, scientists, researchers, lab managers, lab supervisor/directors, principal investigators, principal/associate scientists, QA/QC manager/supervisor, chief scientific officer, VP of research and development (or any decision-making role). Covering both academia, government, and private sector industries.
Certificate of attendance
All webinar participants can request a certificate of attendance, including a learning outcomes summary, for continuing education purposes.
New trends and innovations in automated cell counting
Cell counting remains an essential process across fundamental research, clinical applications and bioproduction.
As science continues to advance, there is a growing demand for faster, higher-throughput, and more tailored cell counting solutions.
While automated techniques address many of these demands, challenges including sample prep, technology compatibility, cost efficiency, and compliance remain.
Recent innovations in software and hardware, including the integration of artificial intelligence and machine learning, focus on enhancing accuracy and efficiency in cell counting.
Karine Labour, Europe Managing Director for Logos Biosystems, will explain how current and developing techniques support researchers reaching the critical milestone of data standardization, accuracy, and reproducibility in cell counting.
Key learning objectives
- Learn about current cell counting challenges, practical solutions using LUNA™ counters, and applications including CAR-T cell therapy production and single cell sequencing
- Understand how the LUNA-FX7™ achieves increased accuracy with higher throughput options, offering added flexibility and increased productivity
- Learn how the new LUNA-III™ cell counter uses machine learning algorithms to ensure high quality and reliable results
Who should attend?
- Students, graduate students, doctoral students, post doc researchers, assistant/associate professors, professors, lab techs, lab specialists, scientists, researchers, lab managers, lab supervisors/directors, principal investigators, principal/associate scientists, QA/QC managers/supervisors, chief scientific officers, VP of research and development (or any decision-making role), and those in both academia, government, and private sector industries.
Certificate of attendance
All webinar participants can request a certificate of attendance, including a learning outcomes summary, for continuing education purposes.
How to master QC in single-cell and nucleus workflows using real-world applications
March 11, 2026 – 15:00 GMT / 16:00 CET / 11:00 ET / 08:00 PT
As single-cell and multiomics technologies continue to reshape our understanding of complex biology, the importance of high-quality sample preparation has never been greater. Reliable quality control (QC) is essential to ensure that valuable samples - often limited and difficult to obtain - yield meaningful, reproducible data. However, researchers working with diverse sample types, such as frozen or FFPE tissue, often face significant QC challenges.
In this SelectScience webinar, experts from both academia and industry share applications and methods to achieve quality control in single-cell and nucleus workflows to ensure the success of downstream applications. This is a critical step for applications such as single-cell RNA sequencing and multiomics analysis.
Using the LUNA-FX7™ automated cell counter, speakers will discuss how to achieve accurate and reproducible samples and master quality control, even with challenging samples containing high debris levels or low yields and share data from a range of sample types including fresh, frozen, fixed and FFPE preparations. In addition, you’ll learn how advanced imaging and algorithm-based classification, like that offered with the LUNA-FX7 supports reliable assessments of nuclei and cell concentration as well as cell viability.
Key learning objectives:
- Explore real-lab applications in both academia and industry to improve sample quality in single-cell and nuclei workflows.
- Gain insights into accurate assessment of sample concentration and viability using the LUNA-FX7™ automated cell counter.
- Learn practical approaches for handling challenging samples such as fixed and FFPE preparations.
Who should attend?
- Students, graduate students, doctoral students, post-doc researchers
- Assistant professors, associate professors, professors
- Lab technicians, lab specialists, scientists, researchers, lab managers, lab supervisors, lab directors, principal investigators, principal/associate scientists
- QA/QC managers and supervisors
- Chief scientific officers (CSOs), VPs of research and development, or any decision-making role covering academia, government, and private sector businesses and industries.
Certificate of attendance
If you attend the live webinar, you will automatically receive a certificate of attendance, including a learning outcomes summary, for continuing education purposes. If you view the on-demand webinar, you can request a certificate of attendance by emailing editor@selectscience.net.
Webinar details
- Cost: Free to attend
- Location: Online
- Duration: 60 minutes
Registration is required to secure your place. If you register but can’t attend live, you will receive a link to the on‑demand recording once it becomes available.
Introducing the LUNA-FL™
This video introduces the Luna FL™ Dual Fluorescence Cell Counter. The deual fluroescence allows for senstive analysis of hard to distinguish cell types, including blood cells.
The Luna-FL™ Dual Fluorescence Cell Counter by Logos Biosystems
Watch this video to learn about the Luna-FL™ Dual Fluorescence Cell Counter, and automated cell counter, integrating bright field and dual fluorescence optics together. Discover how the system provides sensitive and accurate live and dead cell counting results, without limitation of cell type.
Luna-FL™ Dual Fluorescence Automated Cell Counter from Logos Biosystems
This video demonstration introduces the features of the Luna FL Automated Cell Counter from Logos Biosystems. Learn how the system incorporates red and green fluorescence, as well as bright field microscope optics, and is suitable for a range of cell types including blood cells, primary cells, yeast, and standard cell lines.
Automated nuclei QC enhances single cell sequencing
Discover how the latest automated cell counters are critical to successful single cell genomics workflows
Life sciences round-up for 2019
Look back at some of the best life sciences content SelectScience has covered in 2019
Regenerative medicine technique development and the importance of cooperative research
Learn how a new imaging center in South Korea is working to overcome existing experimental limitations with hopes to improve quality of life for patients
Why this cell counter is earning rave reviews from across the scientific spectrum
Scientists define the benefits of the award-winning LUNA-FL from Logos Biosystems and reveal how this dual fluorescence cell counter has helped advance their work
The automated cell counter accelerating personalized animal immunotherapy research
Ferris El-tayyeb discusses the challenges of animal oncology, the lab equipment helping to accelerate progress towards personalized immunotherapies, and his hopes for the future